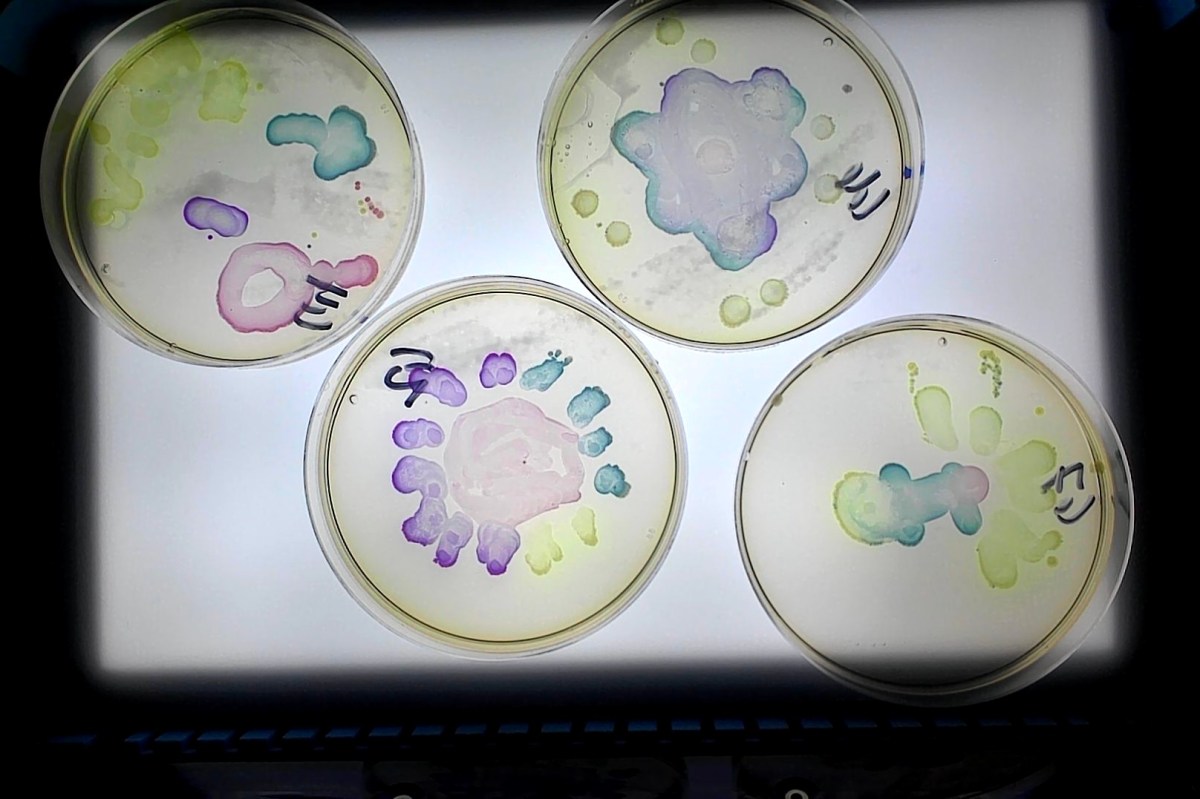
Agar Art A Summer Steam Activity The Official Blog Of Edvotek
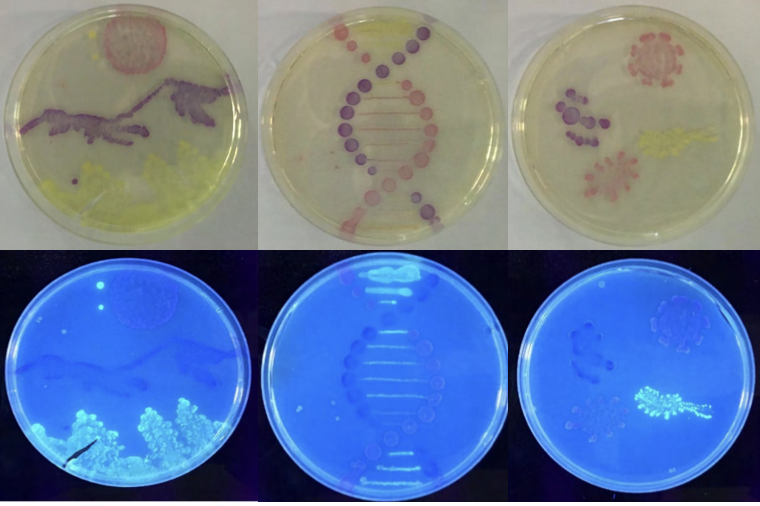
Agar Art A Summer Steam Activity The Official Blog Of Edvotek

Emb Agar Art Agar Art Kit Steam Edvotek
Agar Art A Summer Steam Activity The Official Blog Of Edvotek In this experiment, students create "bio paints" using bacterial culture techniques. the color producing microbes are painted onto an agar plate canvas. after incubation, students will inspect, admire, and hopefully share their living art. In this experiment, students create "bio paints" using bacterial culture techniques. the color producing microbes are painted onto an agar plate canvas. after incubation will inspect, admire, and hopefully share your living art. for 25 students. time required: 60 minutes (plus two incubations).

Agar Art A Summer Steam Activity The Official Blog Of Edvotek Students will harness the color producing power of transformed bacteria to create works of living microbial art. this kit is intended for use in conjunction with edvotek™ transformation kits 222, 223, 224 or 303. At the intersection of art, science, and technology is bio art, the creation of works of art using living matter. in this experiment, students create 'bio paints' using bacterial culture techniques. the color producing microbes are painted onto an agar plate canvas. The kit includes everything you need to create amazing agar art using four different colors of bacteria and has enough materials for 25 agar canvases. while not necessary, an incubator set to 37 ˚c can be used to obtain results in 24 hours or less. Version. sample in this experiment, students will harness the to color producing power of their transformed bacteria to create works of living microbial art. note: this experiment is designed to work in conjunction with edvotek® kits 222, 223, 224 or 303. see page 3 for storage instructions.
Agar Art A Summer Steam Activity The Official Blog Of Edvotek The kit includes everything you need to create amazing agar art using four different colors of bacteria and has enough materials for 25 agar canvases. while not necessary, an incubator set to 37 ˚c can be used to obtain results in 24 hours or less. Version. sample in this experiment, students will harness the to color producing power of their transformed bacteria to create works of living microbial art. note: this experiment is designed to work in conjunction with edvotek® kits 222, 223, 224 or 303. see page 3 for storage instructions. Our equipment is tough enough to stand up to daily use in the research laboratory, but with features that make it easy to use for students and edvotek experiments offer hands on investigations with options for student participation in inquiry based extensions that merge science and education. In this 'agar art' experiment, students create 'bio paints' using bacterial culture techniques. the color producing microbes are painted onto an agar plate canvas. after incubation will inspect, admire, and hopefully share your living art. Browse edvotek's wide range of bacterial transformation and genetic engineering kits. green fluorescent protein (gfp). blue fluorescent protein (bfp). synthetic biology. fermentation. gmo's. c. elegans. In this experiment, students create 'bio paints' using bacterial culture techniques. the color producing microbes are painted onto an agar plate canvas. delivery information: includes four brightly colored biopaints and the material needed for twenty five agar canvases.

Edvotek In The Community Agar Art At The Bayard Rustin Elementary Our equipment is tough enough to stand up to daily use in the research laboratory, but with features that make it easy to use for students and edvotek experiments offer hands on investigations with options for student participation in inquiry based extensions that merge science and education. In this 'agar art' experiment, students create 'bio paints' using bacterial culture techniques. the color producing microbes are painted onto an agar plate canvas. after incubation will inspect, admire, and hopefully share your living art. Browse edvotek's wide range of bacterial transformation and genetic engineering kits. green fluorescent protein (gfp). blue fluorescent protein (bfp). synthetic biology. fermentation. gmo's. c. elegans. In this experiment, students create 'bio paints' using bacterial culture techniques. the color producing microbes are painted onto an agar plate canvas. delivery information: includes four brightly colored biopaints and the material needed for twenty five agar canvases.
Comments are closed.